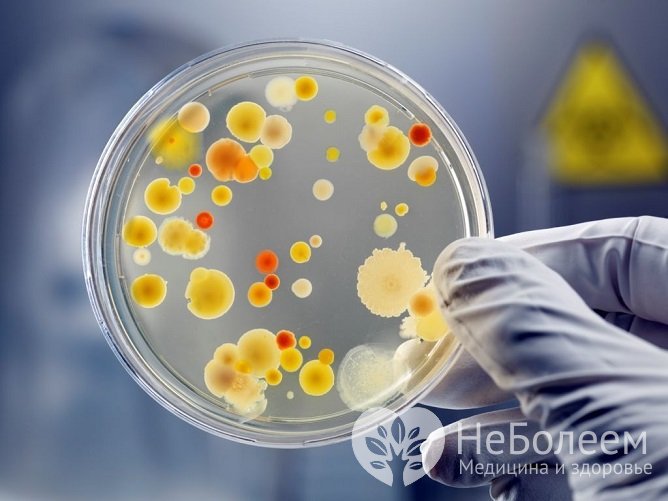
Для выявления возбудителя назначается посев мазка из зева

Воспользуйтесь поиском по сайту:
Ангина у детей: симптомы и лечение, фото горла, признаки, причины
Содержание статьи:
Ангина у детей, или острый тонзиллит – это общее инфекционное заболевание с местными проявлениями в виде острого воспаления одного или нескольких компонентов лимфаденоидного глоточного кольца, преимущественно – небных миндалин.
 Ангина у детей – одна из часто встречающихся ЛОР-патологий
Ангина у детей – одна из часто встречающихся ЛОР-патологийЛечение ангины у детей является непростой задачей, которую лучше доверить специалисту, так как очень часто заболевание переходит в хроническую форму, а также вызывает множество осложнений со стороны разных органов и систем.
Причины ангины
Ангина может быть вызвана бактериальной флорой, вирусами и грибками.
Наиболее частыми возбудителями являются стрептококки, стафилококки, диплококки, пневмококки, энтеровирусы, микоплазмы, хламидии.
 Чаще всего ангину вызывает пиогенный стрептококк
Чаще всего ангину вызывает пиогенный стрептококкЕжегодно в России более 10 млн детей и лиц юношеского возраста переносят инфекции, ассоциированные со стрептококком серологической группы А. Пиогенный стрептококк является факультативно-анаэробным грамположительным микроорганизмом, который способен выделять биологически активные вещества и токсины:
- стрептолизины О и S – токсины, вызывающие гемолиз клеточной мембраны путем внедрения в стенки эритроцитов, лейкоцитов и формирования в них пор;
- цистеин протеаза – фермент, направленный на противодействие иммунной системе, проникновение и распространение в тканях человека;
- стрептокиназа – протеин, способствующий разрушению фибриновых сгустков, что позволяет патогену выходить из зон свернувшейся крови;
- гиалуронидаза, протеаза, липопротеиназа и другие ферменты, способствующие разрушению тканей организма, распространению в них бактерий и проникновению в кровоток.
Передача инфекции происходит преимущественно воздушно-капельным путем, но может быть алиментарный и контактный пути заражения. Источником является человек, больной ангиной, скарлатиной и другими клиническими формами респираторной и кожной стрептококковой инфекции, а также бактерионосители пиогенного стрептококка.
 Бактерии и вирусы обычно передаются воздушно-капельным путем от носителя инфекции
Бактерии и вирусы обычно передаются воздушно-капельным путем от носителя инфекцииКапли после кашля или при чихании, разлетаясь от инфицированного человека, попадают на слизистые оболочки верхних дыхательных путей. Далее запускаются механизмы борьбы этиологического агента с защитными факторами местного иммунитета. Инкубационный период составляет несколько дней.
Острое воспаление миндалин сопровождается выраженным отеком тканей, застоем в лимфатических сосудах и полнокровием. Тромбоз сосудов приводит к образованию микроабсцессов.
Стрептококковая инфекция характеризуется частым развитием аутоиммунных и токсико-септических осложнений.
Возрастные особенности развития миндалин у детей
Важную роль в диагностике и выборе тактики лечения играет знание анатомических и функциональных особенностей у детей разных возрастов.
У грудничка гланды недоразвиты и функционально неактивны, но организм защищен благодаря антителам матери. Лимфоидное кольцо глотки состоит из нескольких тонких складок слизистой оболочки, представляющих собой скопления лимфоцитов. У детей первых месяцев жизни преобладают назофарингиты, а не ангины.
Окончательное развитие фолликулов завершается к концу 1 года. Стимулирующий эффект при этом оказывают бактерии и токсические вещества, действию которых организм начинает подвергаться сразу после рождения.
Для острого тонзиллита характерно увеличение количества лейкоцитов, ускорение СОЭ, появление С-реактивного белка в крови. В общем анализе моче могут появиться следы белка и микрогематурия.
Полного развития миндалины достигают в 2 года или в 3 года. В 4 года многорядный цилиндрический мерцательный эпителий, покрывающий миндалины, начинает замещаться плоским эпителием.
У детей старше 5 лет наблюдается гиперплазия фолликулов миндалин. До 6 лет от свода носоглотки до входа в пищевод цепочкой расположены ретрофарингеальные лимфатические узлы, которые при нагноении приводят к образованию заглоточного абсцесса. Эти лимфатические узлы в дальнейшем атрофируются, поэтому у детей старшего возраста и взрослых не встречается ретрофарингеальный лимфаденит.
В 5–7 лет миндалины достигают предельной величины. Этот возраст характеризуется наибольшей инфекционной заболеваемостью. Увеличение лимфоидной ткани обусловлено интенсивным формированием активного иммунитета с местной выработкой антител.
После 9 лет, по мере накопления в организме антител и совершенствования иммунной системы, начинается возрастная инволюция лимфоидной ткани.
Предрасполагающие факторы
Возникновению острого патологического процесса в миндалинах способствуют различные факторы:
- переохлаждение;
- общее и местное снижение иммунитета;
- запыленность, загазованность воздуха;
- авитаминоз;
- неблагоприятные бытовые условия;
- врожденные иммунодефицитные заболевания;
- патологические процессы в ЛОР-органах;
- аномалии развития;
- оперативные вмешательства на органах верхних дыхательных путей;
- хронические соматические заболевания.
Психосоматика ангины
Психосоматика подразумевает влияние психологических факторов на здоровье человека, провоцируя заболевания. Дети подвержены психосоматике больше, чем взрослые. Это объясняется плохо сформированной психикой ребенка и влиянием родителей.
 Развитие частых ангин связывают с психосоматическими причинами
Развитие частых ангин связывают с психосоматическими причинамиЧасто детей воспитывают по такой модели, когда родители или бабушки, дедушки решают все, не интересуясь желанием и мнением малыша и даже подавляя насильно его сопротивление. В таких случаях за ангиной скрывается желание до последнего отстрочить то действие, которое ребенок не хочет выполнять.
Такое отношение к детям недопустимо и приводит не только к различным патологиям в детстве, но может в дальнейшем влиять на здоровье во взрослой жизни.
Если ребенок часто болеет ангиной, необходимо распознать, чем именно он не хочет заниматься и что его беспокоит.
Таким образом, причиной рецидивирующего острого воспаления миндалин может быть гиперопека и немощность, отсутствие права голоса и слова в семье. Существуют и другие причины: ревность ребенка, дефицит внимания, унижения в школе, на улице, закомплексованность, постоянные ссоры родителей.
Классификация ангин
Ангины встречаются первичные и вторичные.
Первичная ангина, в зависимости от характера и глубины поражения, может быть:
- катаральная;
- лакунарная;
- фолликулярная;
- язвенно-пленчатая;
- комбинированная.
Вторичная ангина встречается при острых инфекционных заболеваниях: дифтерии, скарлатине, кори, туляремии, брюшном тифе, инфекционном мононуклеозе. Также острое воспаление миндалин может развиться при заболеваниях крови: агранулоцитозе, алейкии, лейкозах.
Симптомы ангины у детей
Признаки ангины у детей могут отличаться в разных возрастных группах. Заболевание часто протекает с интоксикационным синдромом.
 Ангина обычно сопровождается повышением температуры тела
Ангина обычно сопровождается повышением температуры телаРебенок становится раздражительным, капризным, отказывается от еды. В результате отека лимфоидной ткани затрудняется глотание, появляется гиперсаливация, неприятный запах во рту. Возможно нарушение дыхания.
Температура тела достигает 38–39 °С, что нередко сопровождается судорогами, рвотой, помрачнением или потерей сознания. Наблюдаются диспепсические явления, чаще всего – боли в животе и жидкий стул.
В 5–7 лет миндалины достигают предельной величины. Этот возраст характеризуется наибольшей инфекционной заболеваемостью.
Выраженность клинических проявлений зависит от разновидности ангины.
Катаральная ангина начинается остро, температура тела чаще всего субфебрильная. У ребенка появляется головная боль, недомогание, ознобы. Дети постарше жалуются на боль в горле, усиливающуюся при глотании. Отмечается увеличение регионарных лимфатических узлов.
При лакунарной и фолликулярной ангине состояние пациентов средней тяжести и тяжелое, температура тела – 38–39 °С и выше, выражены симптомы интоксикации. Боль в горле интенсивная.
Для язвенно-пленчатой ангины характерны умеренные односторонние боли в горле, субфебрильная температура, отсутствие симптомов интоксикации. Регионарный лимфаденит выявляется на стороне поражения.
Читайте также:5 способов снизить температуру без лекарств
Диагностика ангины
При возникновении жалоб у ребенка или изменении его общего состояния необходимо обратиться к врачу: педиатру, инфекционисту или оториноларингологу. Специалист проведет осмотр и назначит необходимые диагностические мероприятия:
- клинический анализ крови;
- общий анализ мочи;
- фарингоскопия;
- мазок из зева на бациллу Леффлера;
- бактериологический посев с миндалин на патологическую флору и чувствительность к антибиотикам.
Для выявления возбудителя назначается посев мазка из зева
Для выявления возбудителя назначается посев мазка из зеваПо показаниям дополнительно определяют С-реактивный белок, ревматоидный фактор, проводится ЭКГ (электрокардиография), рентгенологическое исследование органов грудной клетки, консультация кардиолога, нефролога, невропатолога, стоматолога.
При необходимости госпитализации ребенка помимо перечисленных анализов сдают гемостазиограмму, биохимический анализ крови, исследование кала на яйца глист и простейшие.
При тяжелом течении заболевания или после перенесенной инфекции врач может направить на УЗИ сердца и почек для исключения ревматических осложнений.
Как выглядит ангина, можно посмотреть на фото горла во время фарингоскопии. Характерные признаки разных форм патологии:
- катаральная: отмечается значительная гиперемия слизистой оболочки небных миндалин и прилегающих передних и задних дужек, частично мягкого неба. Язык обложен, сухой;
- лакунарная: на фоне отека и гиперемии слизистой оболочки на миндалинах выявляются беловатые налеты. Налет может располагаться в устьях лакун;
- фолликулярная: отмечается яркая гиперемия и отек слизистой оболочки небных дужек и миндалин. На поверхности миндалин видны множественные беловато-желтоватые нагноившиеся фолликулы округлой формы;
- язвенно-пленчатая: определяется язва на одной из миндалин. Она покрыта серовато-желтым налетом. Изъязвления также могут располагаться на мягком небе, слизистой полости рта, задней стенке глотки.
 Проявления ангины варьируют в зависимости от ее формы
Проявления ангины варьируют в зависимости от ее формыДля острого тонзиллита характерно увеличение количества лейкоцитов, ускорение СОЭ, появление С-реактивного белка в крови. В общем анализе моче могут появиться следы белка и микрогематурия.
Результаты бактериологического посева позволяют определить вид возбудителя и его чувствительность к антибактериальным препаратам. Они становятся известны через 5–6 дней после взятия материала.
 Экспресс-тесты позволяют быстрого выявить пиогенный стрептококк
Экспресс-тесты позволяют быстрого выявить пиогенный стрептококкС целью предварительной дополнительной диагностики наличия бета-гемолитического стрептококка группы А проводятся экспресс-тесты. Экспресс-идентификация основана на определении группоспецифических антигенов стрептококка. Чувствительность и специфичность теста – выше 90%. Это позволяет своевременно назначить этиотропное лечение, что является профилактикой ранних и поздних осложнений стрептококковой инфекции.
Как лечить ангину у ребенка?
Рациональная терапия больных ангиной антибиотиками пенициллинового ряда, к которым стрептококки высокочувствительны, приводит к освобождению организма от возбудителя в течение нескольких суток. Доктор Комаровский подтверждает, что в лечении стрептококкового тонзиллита необходим системный антибиотик.
Назначаются следующие антибактериальные препараты:
Ребенок становится раздражительным, капризным, отказывается от еды. В результате отека лимфоидной ткани затрудняется глотание, появляется гиперсаливация, неприятный запах во рту. Возможно нарушение дыхания.
Можно использовать цефалоспорины 1–2 поколения (Цефуроксим, Цефтриаксон, Цефепим). При наличии аллергии на эти лекарства, назначают макролиды (Азитромицин).
Очень важно принимать антибиотик правильно, следуя рекомендациям врача. Лечение проводится в среднем в течение 7–10 дней.
 При повышенной температуре тела назначаются жаропонижающие средства
При повышенной температуре тела назначаются жаропонижающие средстваЖаропонижающая терапия назначается при температуре тела выше 38,5 °С (Парацетамол, Ибупрофен).
При среднетяжелой и тяжелой степени требуется дезинтоксикационное лечение, которое включает 5% раствор глюкозы, растворы электролитов.
По показаниям назначаются антигистаминные препараты (Супрастин) и муколитики (Ацетилцистеин).
Местно проводится орошение и полоскание горла растворами антисептиков (Гексорал, Ингалипт, Мирамистин, раствор Люголя). Противовоспалительный эффект оказывают частые полоскания горла щелочными и солевыми растворами, отварами ромашки, шалфея, календулы.
Осложнения
Стрептококковый тонзиллит может приводить к ранним и поздним осложнениям, к которым относятся:
- заглоточный абсцесс;
- шейный лимфаденит;
- острый средний отит;
- острый синусит;
- мастоидит;
- острая ревматическая лихорадка с кардитом или без;
- постстрептококковый гломерулонефрит;
- тонзиллогенный сепсис.
У детей заглоточные абсцессы в верхних отделах глотки чаще бывают односторонними, так как в области носоглотки заглоточное пространство разделено связкой на две половины.
Видео
Предлагаем к просмотру видеоролик по теме статьи.
Об авторе

Опыт работы: 4 года работы в частной практике.
Нашли ошибку в тексте? Выделите ее и нажмите Ctrl + Enter.
Каждый человек имеет не только уникальные отпечатки пальцев, но и языка.
























